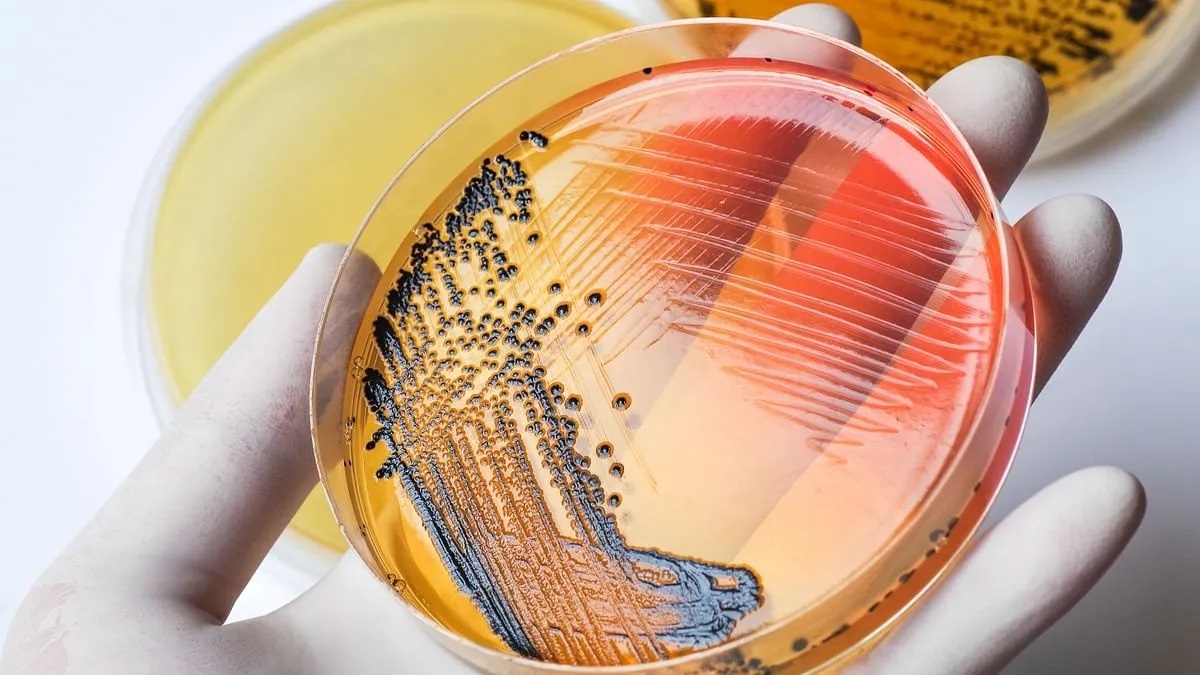

Theo Guardian, dữ liệu cho thấy dưới 50% trẻ em 13-14 tuổi ở Anh đã được tiêm vaccine chống bại liệt vào năm 2021. Con số này được thống kê sau khi giới chức y tế công cộng Vương Quốc Anh thông báo về sự cố quốc gia, do có bằng chứng virus đang lây lan trong cộng đồng.
Tỷ lệ tiêm chủng thấp
Virus bại liệt được phát hiện thông qua giám sát nước thải ở phía bắc và đông London. Đây là virus sống được dùng trong sản xuất vaccine dạng uống ở một số nước. Các chuyên gia đánh giá nguy cơ từ virus này với sức khỏe cộng đồng khá thấp nhưng điều đáng lo ngại là tỷ lệ tiêm vaccine giảm đáng kể trong đại dịch. Điều này có thể tạo cơ hội cho virus tiếp tục lây lan trong cộng đồng.
Dữ liệu chính thức cho thấy chỉ 35% trẻ 13-14 tuổi được tiêm thuốc chống bại liệt ở Hillingdon, phía tây London. Đây là nơi có mức độ bao phủ vaccine thấp nhất cả nước. Ở Brent, 38% nhóm tuổi này được tiêm chủng đầy đủ. 4 khu vực khác là Westminster, Hammersmith và Fulham, Camden và Ealing có tỷ lệ bao phủ dưới 50%.
Phần lớn thanh thiếu niên được tiêm các liều vaccine bại liệt ngay khi còn là trẻ sơ sinh, trẻ nhỏ. Vaccine bảo vệ trẻ khỏi nguy cơ mắc bệnh nghiêm trọng, nhưng mức độ bao phủ thấp khiến khả năng lây nhiễm cao hơn.
 |
| Ngõ Brick, ở phía đông London, nơi các cơ quan y tế Anh tìm thấy bằng chứng về sự lây lan cục bộ của virus bại liệt. Ảnh: Mary Turner/The New York Times. |
Giáo sư Paul Hunter, Đại học East Anglia, Anh, cho biết: “Chúng tôi hy vọng virus sẽ không lây lan thêm, khiến nhiều ca mắc bại liệt trong thời gian tới. Nhưng virus phát tán càng lâu, càng nhiều cơ hội khiến nó trở thành virus độc lực cao lần nữa. Đây sẽ là thảm họa. Những nơi có tỷ lệ tiêm chủng thấp cần phải khẩn trương bao phủ vaccine".
Trên toàn nước Anh, trong giai đoạn 2020-21, tỷ lệ bao phủ của 15/146 địa phương là trên 190%. Vương quốc Anh không có mục tiêu chính thức về việc tiêm phòng nhắc lại ở lứa tuổi thanh thiếu niên, nhưng Tổ chức Y tế Thế giới (WHO) đặt mục tiêu 95% dân số nói chung được tiêm phòng bại liệt đầy đủ.
Cảnh báo về bệnh bại liệt do Cơ quan An ninh Y tế Vương Quốc Anh đưa ra ngày 23/6, sau các cuộc kiểm tra nước thải tại Beckton, Newham, London. Đây là nơi đào thải nước sinh hoạt cho 4 triệu người dân sinh sống ở phía bắc và đông London.
Trường hợp mắc bệnh bại liệt cuối cùng ở Anh là vào năm 1984. Năm 2003, quốc gia này tuyên bố đã xóa sổ bại liệt. Trước khi có vaccine bại liệt, căn bệnh khá phổ biến ở Anh với 8.000 ca mắc mới mỗi năm.
Nguy cơ virus tiến hóa
Theo tiến sĩ Shahin Huseynov, chuyên gia của Tổ chức Y tế Thế giới (WHO), giới chức y tế Anh xác định được virus gây bại liệt (poliovirus) trong một số mẫu nước thải ở London. Phân tích di truyền cho thấy các mẫu có chung nguồn gốc, rất có thể là của một cá nhân đến nước này du lịch vào đầu năm 2022.
Guardian cho hay các mẫu nước thải chứa virus bại liệt dấy lên báo động vì chúng có liên quan đến nhau. 4 mẫu còn lại được cho là ở trẻ em chưa tiêm vaccine. Đặc biệt, chúng chứa các đột biến cho thấy virus đang tiến hóa khi lây lan từ người sang người. Hiện chưa rõ mức độ lây lan của virus, nhưng nó có thể chỉ giới hạn trong một hộ gia đình hoặc một đại gia đình.
Các mẫu được phát hiện ở London đã dấy lên báo động. Bởi chúng có liên quan đến nhau, chứa các đột biến cho thấy virus đang tiến hóa khi lây lan từ người sang người. Nếu nó tiếp tục lây lan, virus bại liệt có thể biến đổi với độc lực mới, gây tê liệt những người chưa được tiêm phòng.
 |
| Các nạn nhân bị bại liệt ở thủ đô Kinshasa của Cộng hòa Dân chủ Congo đang chờ điều trị, ngày 31/7/2006. Ảnh: Reuters. |
Giáo sư Beate Kampmann, Giám đốc Trung tâm Tiêm chủng tại Trường Vệ sinh & Y học Nhiệt đới London, cho biết: “Đó không phải là chuyện xảy ra từ tuần này sang tuần sau mà là phát tán hết người này đến người khác. Nếu virus tiếp tục lây lan, khả năng nó đột biến càng cao".
Theo bà Kampmann, tỷ lệ tiêm chủng vaccine bại liệt tương đối thấp khiến Vương Quốc Anh “dễ bị tổn thương” trước kịch bản như vậy.
Các quan chức y tế đang xác định mức độ lây lan của virus. Có thể nó chỉ giới hạn trong một hộ gia đình hoặc một đại gia đình và vị trí địa lý cụ thể nào đó.
Bộ trưởng Y tế Lord Kamall cho biết các chuyên gia y tế công cộng sẽ “lần theo đường ống nước” để truy tìm nguồn gốc.
“Nó bị trộn lẫn với rất nhiều thứ khác. Những gì chúng tôi phải thử là đi dọc theo đường ống và xem có tìm được nguồn gốc hay không. Trên lý thuyết, có thể tìm thấy các hộ gia đình hoặc đường phố riêng lẻ”, người đứng đầu Bộ Y tế Vương Quốc Anh nói. Chuyên gia y tế cho rằng những mẫu virus mới được phát hiện có nguồn gốc từ một người nào đó đã được tiêm chủng ở nước ngoài.
Chính phủ và NHS khuyến khích phụ huynh tiêm chủng vaccine bại liệt cho con, kêu gọi mọi lứa tuổi chưa tiêm vaccine hãy tiêm ngay khi có thể.